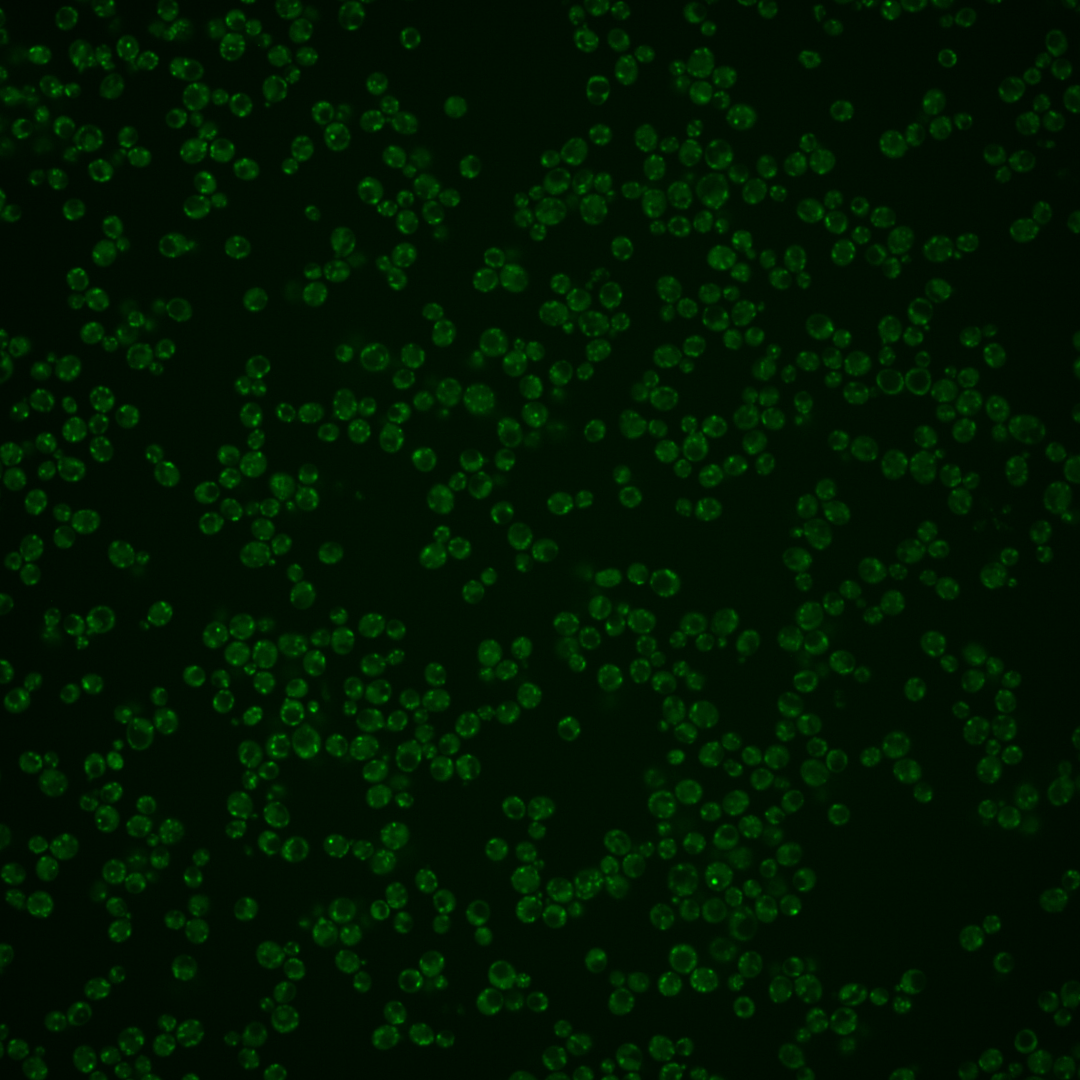
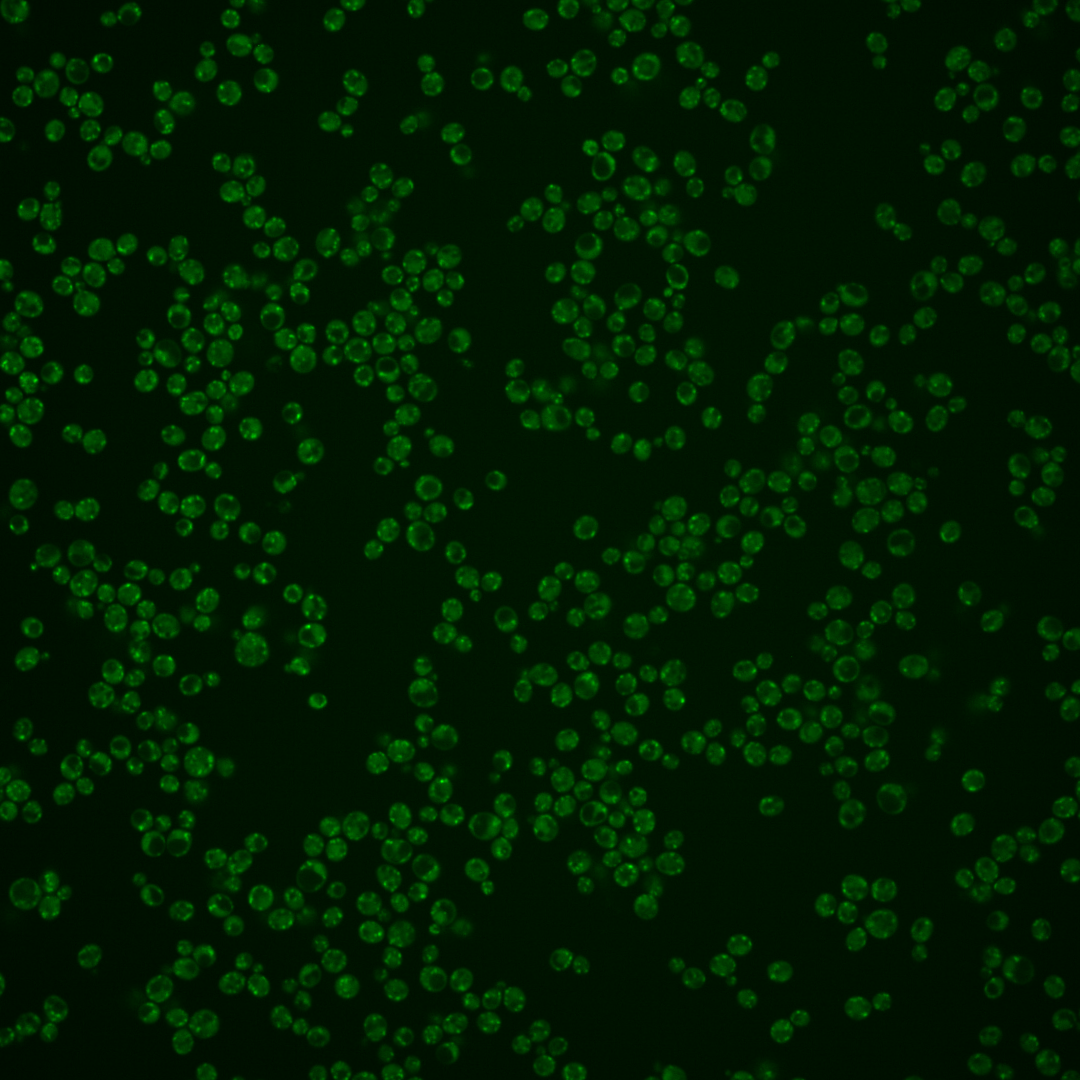
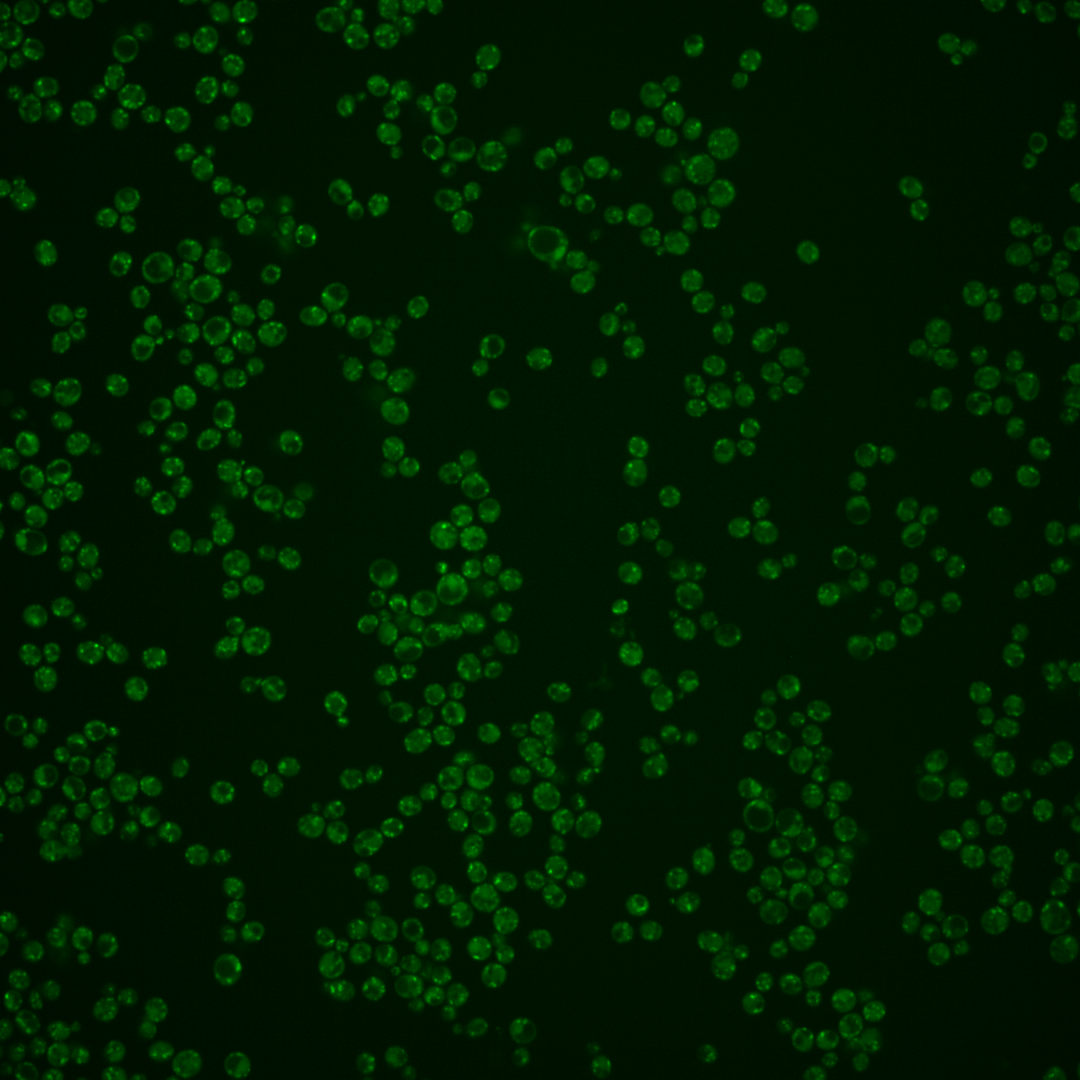

| Standard name | |
|---|---|
| Human Ortholog | |
| Description | Component of the conserved oligomeric Golgi complex; a cytosolic tethering complex (Cog1p through Cog8p) that functions in protein trafficking to mediate fusion of transport vesicles to Golgi compartments |
Micrographs




















































































Sub-cellular Localization
Yeast GFP Assignment
Protein Abundance
Localization Change
External localization resources
| ensLOC | DeepLoc | |||||||||||||||||||||||
|---|---|---|---|---|---|---|---|---|---|---|---|---|---|---|---|---|---|---|---|---|---|---|---|---|
| Localization | WT1 | WT2 | WT3 | RAP60 | RAP140 | RAP220 | RAP300 | RAP380 | RAP460 | RAP540 | RAP620 | RAP700 | HU80 | HU120 | HU160 | rpd3Δ_1 | rpd3Δ_2 | rpd3Δ_3 | WT1 | WT2 | WT3 | AF100 | AF140 | AF180 |
| Cortical Patches | 19 | 32 | 3 | – | 1 | 0 | 0 | 1 | 0 | 2 | 0 | 0 | 5 | 3 | 4 | 16 | 16 | 8 | 2 | 12 | 1 | 12 | 21 | 22 |
| Bud | 2 | 8 | 6 | – | 0 | 4 | 5 | 3 | 4 | 9 | 7 | 7 | 6 | 3 | 8 | 7 | 1 | 1 | 0 | 0 | 0 | 0 | 0 | 0 |
| Bud Neck | 0 | 0 | 0 | – | 0 | 0 | 0 | 0 | 1 | 0 | 0 | 0 | 0 | 0 | 0 | 0 | 0 | 0 | 0 | 0 | 0 | 0 | 0 | 0 |
| Bud Site | 0 | 0 | 0 | – | 0 | 0 | 0 | 2 | 2 | 2 | 1 | 2 | 0 | 0 | 0 | 0 | 0 | 0 | – | – | – | – | – | – |
| Cell Periphery | 1 | 4 | 1 | – | 0 | 2 | 0 | 1 | 0 | 0 | 0 | 0 | 0 | 2 | 1 | 2 | 0 | 2 | 0 | 0 | 0 | 0 | 0 | 1 |
| Cytoplasm | 4 | 33 | 4 | – | 3 | 5 | 9 | 24 | 8 | 13 | 9 | 9 | 17 | 26 | 21 | 10 | 10 | 8 | 0 | 5 | 5 | 0 | 0 | 3 |
| Endoplasmic Reticulum | 11 | 41 | 0 | – | 0 | 0 | 1 | 0 | 5 | 0 | 0 | 0 | 17 | 20 | 23 | 12 | 4 | 5 | 0 | 3 | 0 | 1 | 3 | 5 |
| Endosome | 12 | 13 | 17 | – | 10 | 16 | 12 | 23 | 3 | 0 | 0 | 0 | 12 | 50 | 26 | 16 | 27 | 15 | 20 | 52 | 15 | 25 | 35 | 28 |
| Golgi | 74 | 102 | 14 | – | 1 | 0 | 1 | 5 | 1 | 1 | 0 | 0 | 92 | 179 | 82 | 63 | 64 | 42 | 135 | 264 | 62 | 168 | 312 | 282 |
| Mitochondria | 126 | 253 | 45 | – | 24 | 86 | 123 | 102 | 140 | 138 | 88 | 88 | 283 | 229 | 286 | 16 | 15 | 8 | 13 | 70 | 18 | 37 | 43 | 24 |
| Nucleus | 1 | 0 | 1 | – | 0 | 0 | 3 | 4 | 0 | 5 | 3 | 3 | 0 | 2 | 2 | 1 | 0 | 0 | 0 | 0 | 0 | 0 | 0 | 0 |
| Nuclear Periphery | 0 | 1 | 0 | – | 0 | 0 | 0 | 0 | 0 | 0 | 2 | 2 | 1 | 0 | 2 | 3 | 1 | 2 | 0 | 2 | 1 | 0 | 0 | 0 |
| Nucleolus | 1 | 0 | 1 | – | 0 | 4 | 0 | 0 | 0 | 0 | 1 | 1 | 1 | 0 | 2 | 1 | 2 | 0 | 0 | 0 | 0 | 0 | 0 | 0 |
| Peroxisomes | 0 | 1 | 1 | – | 1 | 6 | 4 | 9 | 4 | 0 | 1 | 1 | 1 | 3 | 1 | 0 | 0 | 0 | 3 | 5 | 3 | 14 | 27 | 14 |
| SpindlePole | 0 | 2 | 4 | – | 2 | 0 | 4 | 10 | 1 | 5 | 2 | 2 | 2 | 2 | 2 | 5 | 5 | 2 | 0 | 2 | 0 | 1 | 1 | 0 |
| Vac/Vac Membrane | 12 | 25 | 15 | – | 7 | 9 | 6 | 12 | 7 | 12 | 3 | 2 | 15 | 42 | 21 | 15 | 20 | 11 | 2 | 22 | 1 | 2 | 3 | 1 |
| Unique Cell Count | 168 | 368 | 80 | 36 | 108 | 144 | 155 | 154 | 153 | 101 | 100 | 351 | 441 | 384 | 133 | 123 | 83 | 183 | 446 | 114 | 266 | 454 | 391 | |
| Labelled Cell Count | 263 | 515 | 112 | 49 | 132 | 168 | 196 | 176 | 187 | 117 | 117 | 452 | 561 | 481 | 167 | 165 | 104 | 183 | 446 | 114 | 266 | 454 | 391 | |
Yeast GFP Assignment
Protein Abundance
| Screen | WT1 | WT2 | WT3 | RAP60 | RAP140 | RAP220 | RAP300 | RAP380 | RAP460 | RAP540 | RAP620 | RAP700 | HU80 | HU120 | HU160 | rpd3Δ_1 | rpd3Δ_2 | rpd3Δ_3 | AF100 | AF140 | AF180 |
|---|---|---|---|---|---|---|---|---|---|---|---|---|---|---|---|---|---|---|---|---|---|
| Mean Cell GFP Intensity (1e-4) | 8.0 | 7.2 | 7.5 | – | 7.4 | 5.9 | 5.8 | 6.7 | 5.2 | 4.8 | 4.6 | 4.6 | 7.4 | 7.7 | 7.2 | 9.2 | 9.5 | 9.0 | 6.8 | 7.1 | 7.6 |
| Std Deviation (1e-4) | 1.0 | 1.2 | 1.4 | – | 1.9 | 1.3 | 1.4 | 2.1 | 1.3 | 1.3 | 1.2 | 1.2 | 1.0 | 1.2 | 1.2 | 1.8 | 1.9 | 1.9 | 1.1 | 1.1 | 1.3 |
| Intensity Change (Log2) | – | – | – | – | -0.02 | -0.36 | -0.37 | -0.16 | -0.54 | -0.64 | -0.72 | -0.72 | -0.03 | 0.03 | -0.06 | 0.29 | 0.33 | 0.26 | -0.14 | -0.09 | 0.01 |
Localization Change
| Localization | RAP60 | RAP140 | RAP220 | RAP300 | RAP380 | RAP460 | RAP540 | RAP620 | RAP700 | HU80 | HU120 | HU160 | rpd3Δ_1 | rpd3Δ_2 | rpd3Δ_3 |
|---|---|---|---|---|---|---|---|---|---|---|---|---|---|---|---|
| Cortical Patches | – | 0 | 0 | 0 | 0 | 0 | 0 | 0 | 0 | 0 | 0 | 0 | 2.1 | 2.2 | 1.5 |
| Bud | – | 0 | 0 | 0 | 0 | 0 | 0 | 0 | 0 | 0 | 0 | 0 | 0 | 0 | 0 |
| Bud Neck | – | 0 | 0 | 0 | 0 | 0 | 0 | 0 | 0 | 0 | 0 | 0 | 0 | 0 | 0 |
| Bud Site | – | 0 | 0 | 0 | 0 | 0 | 0 | 0 | 0 | 0 | 0 | 0 | 0 | 0 | 0 |
| Cell Periphery | – | 0 | 0 | 0 | 0 | 0 | 0 | 0 | 0 | 0 | 0 | 0 | 0 | 0 | 0 |
| Cytoplasm | – | 0 | 0 | 0 | 2.4 | 0 | 1.0 | 1.0 | 1.0 | 0 | 0 | 0 | 0.7 | 0.9 | 1.1 |
| Endoplasmic Reticulum | – | 0 | 0 | 0 | 0 | 0 | 0 | 0 | 0 | 0 | 0 | 0 | 0 | 0 | 0 |
| Endosome | – | 0.8 | -1.1 | -2.8 | -1.2 | -5.0 | 0 | 0 | 0 | -5.7 | -2.4 | -4.1 | -1.8 | 0.1 | -0.5 |
| Golgi | – | 0 | -4.5 | -4.8 | -3.8 | -5.0 | 0 | 0 | 0 | 1.6 | 3.9 | 0.8 | 4.4 | 4.9 | 4.4 |
| Mitochondria | – | 1.1 | 3.4 | 4.8 | 1.4 | 6.2 | 0 | 0 | 0 | 4.6 | -0.7 | 3.3 | -6.9 | -6.7 | -6.4 |
| Nucleus | – | 0 | 0 | 0 | 0 | 0 | 0 | 0 | 0 | 0 | 0 | 0 | 0 | 0 | 0 |
| Nuclear Periphery | – | 0 | 0 | 0 | 0 | 0 | 0 | 0 | 0 | 0 | 0 | 0 | 0 | 0 | 0 |
| Nucleolus | – | 0 | 0 | 0 | 0 | 0 | 0 | 0 | 0 | 0 | 0 | 0 | 0 | 0 | 0 |
| Peroxisomes | – | 0 | 0 | 0 | 0 | 0 | 0 | 0 | 0 | 0 | 0 | 0 | 0 | 0 | 0 |
| SpindlePole | – | 0 | 0 | 0 | 0 | 0 | 0 | 0 | 0 | 0 | 0 | 0 | 0 | 0 | 0 |
| Vacuole | – | 0.1 | -2.1 | -3.6 | -2.5 | -3.5 | -2.5 | -3.5 | -3.8 | -4.6 | -2.4 | -4.0 | -1.5 | -0.5 | -1.0 |
External localization resources
Images






























Protein Concentration and Protein Localization Data
| R1 | R2 | R3 | ||||||||||||||||
|---|---|---|---|---|---|---|---|---|---|---|---|---|---|---|---|---|---|---|
| G1 Pre-START | G1 Post-START | S/G2 | Metaphase | Anaphase | Telophase | G1 Pre-START | G1 Post-START | S/G2 | Metaphase | Anaphase | Telophase | G1 Pre-START | G1 Post-START | S/G2 | Metaphase | Anaphase | Telophase | |
| Concentration | 4.2678 | 5.4524 | 4.8882 | 4.2125 | 4.3259 | 4.686 | 3.9712 | 4.6361 | 4.414 | 3.9614 | 4.0987 | 4.237 | 2.6694 | 3.4061 | 3.0126 | 2.5226 | 2.6531 | 2.8153 |
| Actin | 0.0325 | 0.0175 | 0.0154 | 0.0101 | 0.0285 | 0.0063 | 0.0184 | 0.0035 | 0.0248 | 0.0255 | 0.0037 | 0.003 | 0.0187 | 0.0068 | 0.0028 | 0.0006 | 0.001 | 0.0111 |
| Bud | 0.0006 | 0.0014 | 0.0004 | 0.0002 | 0.0004 | 0.0002 | 0.0004 | 0.0002 | 0.0007 | 0.0002 | 0.0005 | 0.0001 | 0.0001 | 0.0004 | 0.0001 | 0.0001 | 0.0001 | 0.0002 |
| Bud Neck | 0.0015 | 0.0011 | 0.0022 | 0.0014 | 0.0177 | 0.0004 | 0.0009 | 0.0002 | 0.0012 | 0.0008 | 0.0003 | 0.0004 | 0.0008 | 0.0002 | 0.0002 | 0.0001 | 0.0001 | 0.0004 |
| Bud Periphery | 0.0008 | 0.0014 | 0.0004 | 0.0001 | 0.0004 | 0.0002 | 0.0004 | 0.0001 | 0.0008 | 0.0002 | 0.0015 | 0.0002 | 0.0001 | 0.0003 | 0.0001 | 0 | 0 | 0.0001 |
| Bud Site | 0.0029 | 0.0096 | 0.0024 | 0.0004 | 0.0012 | 0.0004 | 0.0037 | 0.0049 | 0.004 | 0.0013 | 0.0005 | 0.0001 | 0.0004 | 0.0006 | 0.0002 | 0.0001 | 0.0001 | 0.0002 |
| Cell Periphery | 0.0003 | 0.0004 | 0.0006 | 0.0001 | 0.0002 | 0.0001 | 0.0001 | 0 | 0.0002 | 0.0001 | 0.0001 | 0 | 0.0001 | 0 | 0 | 0 | 0 | 0 |
| Cytoplasm | 0.0081 | 0.0155 | 0.0061 | 0.0033 | 0.0038 | 0.0057 | 0.0125 | 0.0077 | 0.0051 | 0.0068 | 0.005 | 0.0031 | 0.0059 | 0.0088 | 0.0076 | 0.0068 | 0.0099 | 0.0072 |
| Cytoplasmic Foci | 0.1154 | 0.1356 | 0.0822 | 0.0768 | 0.1003 | 0.0648 | 0.0955 | 0.1072 | 0.0869 | 0.0848 | 0.0743 | 0.063 | 0.0851 | 0.1175 | 0.0923 | 0.0811 | 0.0847 | 0.0771 |
| Eisosomes | 0.0004 | 0.0002 | 0.0006 | 0 | 0.0002 | 0.0001 | 0.0001 | 0 | 0.0001 | 0.0001 | 0.0001 | 0 | 0.0001 | 0 | 0 | 0 | 0 | 0 |
| Endoplasmic Reticulum | 0.007 | 0.0016 | 0.0016 | 0.0009 | 0.0011 | 0.0036 | 0.0029 | 0.0007 | 0.0011 | 0.0017 | 0.0037 | 0.0011 | 0.0013 | 0.0008 | 0.0012 | 0.0009 | 0.0012 | 0.0011 |
| Endosome | 0.251 | 0.3068 | 0.2766 | 0.3298 | 0.2944 | 0.2502 | 0.232 | 0.2254 | 0.2216 | 0.3133 | 0.3382 | 0.1788 | 0.356 | 0.3122 | 0.3155 | 0.4573 | 0.3967 | 0.2328 |
| Golgi | 0.4051 | 0.4269 | 0.5138 | 0.5414 | 0.4382 | 0.5292 | 0.553 | 0.6257 | 0.6042 | 0.4731 | 0.4858 | 0.7315 | 0.4858 | 0.5301 | 0.554 | 0.4401 | 0.4568 | 0.6163 |
| Lipid Particles | 0.0562 | 0.016 | 0.0092 | 0.0051 | 0.0145 | 0.0265 | 0.0082 | 0.0023 | 0.0044 | 0.0338 | 0.008 | 0.0011 | 0.0049 | 0.0035 | 0.0018 | 0.0022 | 0.0029 | 0.006 |
| Mitochondria | 0.0556 | 0.036 | 0.0565 | 0.0216 | 0.0542 | 0.0807 | 0.0404 | 0.0155 | 0.0281 | 0.0398 | 0.0508 | 0.0142 | 0.0252 | 0.0103 | 0.0179 | 0.0039 | 0.0394 | 0.0368 |
| None | 0.0118 | 0.0056 | 0.0121 | 0.0001 | 0.0021 | 0.0113 | 0.0033 | 0.0007 | 0.0002 | 0.0005 | 0.0008 | 0 | 0.001 | 0.0001 | 0.0001 | 0.0001 | 0.0005 | 0.003 |
| Nuclear Periphery | 0.003 | 0.0004 | 0.0005 | 0.0001 | 0.0003 | 0.002 | 0.0047 | 0.0002 | 0.0023 | 0.0005 | 0.0112 | 0.0001 | 0.0003 | 0.0001 | 0.0001 | 0.0002 | 0.0001 | 0.0003 |
| Nucleolus | 0.0006 | 0.0005 | 0.0004 | 0 | 0.007 | 0.0003 | 0.0007 | 0.0001 | 0.0002 | 0.0009 | 0.0001 | 0 | 0.0001 | 0 | 0 | 0 | 0 | 0 |
| Nucleus | 0.0007 | 0.0004 | 0.0004 | 0.0001 | 0.0028 | 0.0006 | 0.0036 | 0.0001 | 0.0004 | 0.0003 | 0.0005 | 0.0001 | 0.0001 | 0 | 0 | 0 | 0 | 0.0001 |
| Peroxisomes | 0.0324 | 0.0166 | 0.013 | 0.0047 | 0.016 | 0.0095 | 0.0082 | 0.002 | 0.0057 | 0.0065 | 0.0022 | 0.0011 | 0.0056 | 0.0055 | 0.0028 | 0.0011 | 0.0014 | 0.0037 |
| Punctate Nuclear | 0.0079 | 0.0005 | 0.0012 | 0.0001 | 0.0097 | 0.0021 | 0.0024 | 0.0015 | 0.0009 | 0.0022 | 0.0004 | 0 | 0.0035 | 0.0001 | 0.0001 | 0.0001 | 0.0001 | 0.0002 |
| Vacuole | 0.0036 | 0.0039 | 0.0025 | 0.0013 | 0.0041 | 0.0031 | 0.0039 | 0.0008 | 0.0046 | 0.0046 | 0.0042 | 0.0007 | 0.0024 | 0.0013 | 0.0015 | 0.002 | 0.0023 | 0.0014 |
| Vacuole Periphery | 0.0027 | 0.0022 | 0.0021 | 0.0023 | 0.003 | 0.0028 | 0.0047 | 0.001 | 0.0027 | 0.003 | 0.0082 | 0.0013 | 0.0027 | 0.0015 | 0.0017 | 0.003 | 0.0025 | 0.002 |
Sequencing Data
| R1 | R2 | |||||||||
|---|---|---|---|---|---|---|---|---|---|---|
| G1 Post-START | S/G2 | Metaphase | Anaphase | Telophase | G1 Post-START | S/G2 | Metaphase | Anaphase | Telophase | |
| Gene Expression | 22.3308 | 18.0053 | 13.9416 | 22.3045 | 21.005 | 18.8175 | 24.1416 | 26.1771 | 21.6118 | 24.7686 |
| Translational Efficiency | 0.9779 | 1.0509 | 1.1257 | 0.7193 | 0.7153 | 0.9956 | 0.8475 | 0.5628 | 0.7984 | 0.8395 |
Hit Data
| Dataset | Hit |
|---|---|
| Protein Concentration | ✘ |
| Protein Localization | ✘ |
| Gene Expression | ✘ |
| Translational Efficiency | ✘ |
Endocytosis
| Temp | Actin Patch (Sac6-tdTomato) | Cortical Patch (Sla1-GFP) | Late Endosome (Snf7-GFP) | Vacuole (Vph1-GFP) |
|---|---|---|---|---|
| 37℃ | ||||
| RT |
Cell Cycle Omics
CYCLoPs (Cog6-GFP)
| Gene / Allele | Actin Patch (Sac6-tdTomato) | Cortical Patch (Sla1-GFP) | Late Endosome (Snf7-GFP) | Vacuole (Sac6-tdTomato) |
|---|
| Gene | Images |
|---|
| Gene | Images |
|---|
Images are not yet available
Images are not yet available